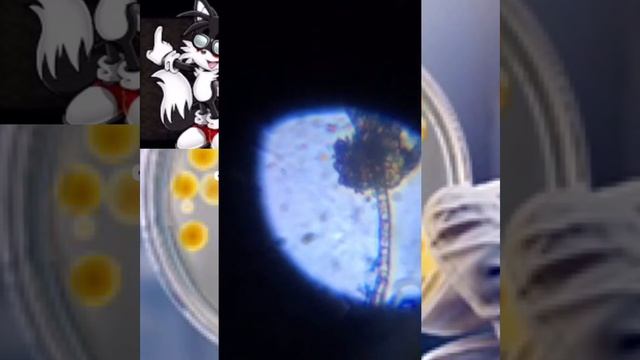
Речные водоросли под микроскопом

Уют и комфорт в доме - Новые видео
-
-
Речные водоросли под микроскопом
Музыка : в начале милая Музыка, в конце Voyage Микроскоп: levenhuk LabZZ m101 + моя модификация Около 200х
Смотреть -
Бег по граблям с препятствиями
ХОТИТЕ ЗАРАБАТЫВАТЬ 1000$$ И БОЛЕЕ? ? ПРИХОДИТЕ В МОЮ КОМАНДУ! ⭐МЫ ОБЪЕДИНЯЕМ ЛУЧШИХ!⭐ Заполняйте форму и я свяжусь с Вами https://vk.cc/5VrMko Меня зо...
Смотреть -
Погрузчик фаворит 800 ПАЛЕХАГРОМАШ
Мы производим: Погрузчики: https://www.youtube.com/watch?v=d0zsV5VW8P4&t=6s Отвалы на трактор: https://www.youtube.com/watch?v=y0ylpFgU2uw&t=1s Отвальны...
Смотреть -
ASSASSIN'S CREED VALHALLA ВАЛЬГАЛЛА #12 ? Xbox SX ОРДЕН ДРЕВНИХ. Прохождение на русском.
Раны новых друзей. Деголас Прекрасный. Прохождение игры ASSASSIN'S CREED VALHALLA ВАЛЬГАЛЛА на русском языке на Xbox SX. Всем приятного просмотра. Плейл...
Смотреть -
Как сделать платный тренинг?
Картинка тут: http://www.slideshare.net/psystart/ss-52353366 Подробнее тут: http://psystart.pro/event/psystart-startwebinar.html Выдержка из семинара ...
Смотреть -
ШОУ ТАКСИ || ШОУ ТАКСИ В САМПЕ || ARIZONA BRAINBURG #1
Мой никнейм - Fawellen_Bulls - При достижение 5 лвл вам даст 300.000$ . Так же вводите мой промокод #Fawellen Жду вас на сервере Arizona BRAINBURG! I...
Смотреть -
-
-
-
Как питаться, чтобы сохранить здоровье и молодость
К чему приводит употребление продуктов, изготовленных более месяца назад? Как на нашем здоровье сказывается принятая в обществе культура питания? Садхгу...
Смотреть -
-
Минитрактор MITSUBISHI MT460
Показ работы минитрактор MITSUBISHI MT460 Артикул Т0351 http://www.clrus.ru/node/750 Другая спецтехника http://www.clrus.ru
Смотреть -
-
Проверяю итоговые сочинения подписчиков онлайн! 08.11.2020 [Запись трансляции]
Донат через суперчат или через этот сервис: http://www.donationalerts.ru/r/irish_u Всем привет! На этой трансляции я буду проверять и комментировать со...
Смотреть -
Г. Игнатов. Россия начинает выход из карантина — причины и следствия
Г. Игнатов. Россия начинает выход из карантина — причины и следствия https://jpgazeta.ru/rossiya-nachinaet-vyhod-iz-karantina-prichiny-i-sledstviya/ ка...
Смотреть -
-
РАЗОБЛАЧЕНИЕ Wildberries. Серия 1
Запись на обучение Wildberries/Ozon в Direct: https://www.instagram.com/sudarev_gleb/ В этом видео я делюсь с вами тем, что не расскажут другие. Раск...
Смотреть -
145 День. Грабли не прощаются с тобой / Новая жизнь в новом доме
145 День. Грабли не прощаются с тобой / Новая жизнь в новом доме. Переезд в Краснодарский край станица Динская. Мы, Ольга и Александр Грабельниковы, в ...
Смотреть -

![Проверяю итоговые сочинения подписчиков онлайн! 08.11.2020 [Запись трансляции]](https://pic.rtbcdn.ru/video/12/16/12165a42627422a6776547a6bf8815d1.jpg)




